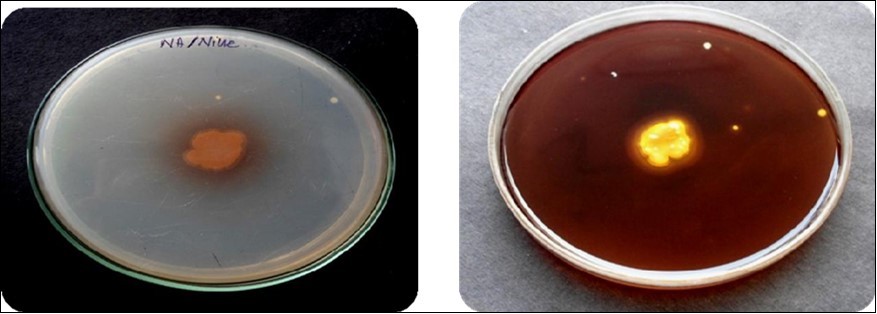
Plate

Optimization, Production, Purification of Laccase Enzyme from Bacillus sp
Abstract
Laccase enzyme production is important and more beneficial for environment, because it has many roles like, involved in bioremediation, biodegradation, decolorization of environmental polluted dyes and pharmaceutical sector also. Production of laacse enzyme from bacillus sp as using of Agro waste (rice bran) as a substrate. The Agricultural soil sample was collected, after the sample were processed for the preliminary and biochemical tests to identification of Bacillus organism. The Guiacol inducer were used for microbial screening of laccase enzyme production. After that microbial screening, various optimization parameters (pH, Temperature, Inducers, carbon and nitrogen sources) are checked for that production of laccase enzyme in mass level. Based on that optimization the bulk fermentation (large scale) (solid state fermentation) were done as a rice bran substrate. The fermentation product was subjected to analyzed the physiochemical properties and purification based on that techniques of Gel filtration chromatography, Dialysis, Ammonium sulfate preciptation. The protein estimation of that product to analysed by lowry’s method.
Author Contributions
Academic Editor: Fuwen Yuan, Duke University, United States.
Checked for plagiarism: Yes
Review by: Single-blind
Copyright © 2020 Nivedharshini Tamilvanan
This is an open-access article distributed under the terms of the Creative Commons Attribution License, which permits unrestricted use, distribution, and reproduction in any medium, provided the original author and source are credited.
Competing interests
The authors have declared that no competing interests exist.
Citation:
Introduction
Laccase are the copper containing enzyme that catalyze the oxidation of wide variety of organic and in organic substrates, including Mono, Di and Poly phenols, Methoxy phenols, aromatic amines and ascorbate that oxidizes the four electrons to the reduction of oxygen to water 1
Laccase are identified from higher plants, fungal species, bacterial species and insects genera also having different functions in wide variety of species, the role of laccase varies from species to one another. They are involved in lignin biosynthesis and lignin degradation, pigment formation in fungal Spores, plant pathogenesis and as well as fungal virulence factors in iron catabolism and kernel brewning process in plants 2
The laccase were involved in many functions based on their various source. ISt will derived from plant, fungi, bacteria, insects. Having unique functional roles, based on that source. laccase was first reported in that bacterium Azospirillium lipoferum, it plays a important role in cell pigmentation, oxidation of phenolic compounds 3. In that present study was mainly focused on that bacterial sp, especially in that Bacillus sp.
In the laccase having a wide variety of applications in different fields such that, Biotechnological applications 4, Anti cancer drugs 5, storage of food products in food industries 6, Degradation of lignin in paper and pulp industries 7, Bleaching purpose in textile industry 8, cosmetics and personal hygine products 9.
Materials and Methods
Microorganism Isolation and Identification
The agricultural soil samples were collected from Namakkal district in around zones and processed for serial dilution and were plated on the Nutrient agar and incubated at 37⁰C for 24 to 48 hours. The obtained microbial colonies were isolated and identified by basic techniques based on preliminary and biochemical tests.
Screening of Laccase Producing Microorganisms by Plate Assay Plate Assay
A loop full of culture was inoculated on the center of nutrient agar plates containing 1% of guiacol that were incubated at 37⁰C for 24 hours 10.
Optimization of Laccase Enzyme Production
Optimization process were done by using of rice bran as a substrate and adding of Mineral Salt Medium (Peptone, Dextrose, Dipotassium hydrogen phosphate, Potassium dihydrogen phosphate, Magenisum sulphate), Ferrous sulphate, Zinc sulphate and then using various parameters like pH, Temperature, Carbon source, Nitrogen source and different incubation periods, Inducers.
Then varying parameters such as pH, temperature, incubation periods,carbon and nitrogensources and inducers.the different conditions werev tested were the following: pH (2, 5, 7, 8, 10), temperature (25⁰ C, 28⁰ C, 37⁰ C, 50⁰ C, 60⁰ C), Incubation periods (16, 24, 48, 96,and 120 hours).Also the utilization of different Carbon sources (Glucose, Sucrose, Starch, Maltose, Lactose) Nitrogen sources (Potassium Nitrate, Sodium Nitrate, Peptone, Urea, Beef extract), and inducers ( Guiacol, ABTS, CuSO4, Pyrocatechcol, Syringaldazine) were checked.
Plate Assay and Spectrometric Analysis
After that optimization procedure taken the extracts taken by filtration on Whatmann no 1 paper and centrifugation at 5000rpm for 5 minutes, were processed by the plate assay method to followed the 10 techniques. After incubation, the laccase production was confirmed by the zone formation around the optimum wells. The supernatant are using for UV-spectrometer analysis (720nm) for identifying high laccase activity.
Bulk Fermentation
The solid state fermentation were done by using of rice bran as a substrate and adding of Mineral Salt Solution and then high laccase activity occurring parameters are used for the bulk fermentation.
Purification Process
Ammonium Sulphate Precipitation
The ammonium sulphate (60% saturation) was added to culture filtrate and incubated at 4°C for overnight. The precipitate, separated by centrifugation at 8000 rpm for 20 min and dissolved in 0.05 M citrate buffer pH- 5.0,was dialysed against the same buffer at 4°C 11.
Gel Filtration Chromatography
The dialyzed enzyme fraction was further purified as per the standard method with certain modifications. It was loaded on sephadex G- 100 column (10.5×1.5 cm, bed volume 65 ml) and eluted with 0.01M Tris-HCl buffer (pH 6.0) with the flow rate of 20 ml/h. Total 40 fractions of 3 ml each were subsequently collected. The fractions showing higher enzyme activity were pulled together for further characterization 12.
Protein Estimation
Lowry’s Method was used for the estimation of protein in the sample. A standard quantitative assay for determining the protein content in a solution was used. BSA was used as a reference for protein assay 13.
Laccase Assay
Oxidation of guaiacol has been reported for laccase assay by 14. The reddish brown color developed due to oxidation of guaiacol by laccase is used to measure enzyme activity at 450 nm. Figure 1, Table 1 and Table 2.
Table 1. Preliminary Tests| S.No | Preliminary | Result |
|---|---|---|
| 1 | Oxidase test | Positive (+ve) |
| 2 | Catalase test | Positive (+ve) |
| 3 | Gram staining test | Gram Positive rod (+ve) |
| 4 | Motility test | Motile rod |
| S.No | Biochemical Tests | Result |
| 1 | Indole test | Negative (-ve) |
| 2 | Methyl red test | Negative (-ve) |
| 3 | Voges proskauer test | Positive (+ve) |
| 4 | Citrate test | Positive (+ve) |
| 5 | Triple sugar iron test | Positive (+ve) (A+/A+) |
| 6 | Urease test | Negative (-ve) |
| 7 | Carbohydrate fermentation test(glucose, sucrose, lactose, mannitol) | Positive (+ve) (A+/G-) |
Results and Discussion
Assay
In the plate assay method laccase enzyme production were identified by orange to brown halos are formed.
Optimization and Spectrometric Analysis
Optimization were done by using of various nutrient sources such as carbon, nitrogen, pH, Temperature, inducers and Incubation periods and then zone formation are occurring in all parameters and large size of zone that is more yield occurs. except some parameters like starch, KNO3, 16 hours, CuSo4, pH 2, 28⁰C. Figure 2, Figure 3, Figure 4, Figure 5, Figure 6, Figure 7, Table 3.
Figure 5.Hydrogen Ion Concentration (Ph)
Figure 7.Enzyme Activity ( From Crude Enzyme Tom Partial Purification)
| Purification steps | Laccase Enzymes U/ml | Protein mg/ml | Specific Activity U/mg | Purification Fold | Recovery (%) |
| Crude extract | 2230 | 620 | 3.6 | 1 | 100 |
| Ammonium sulphate precipitation | 1760 | 374 | 4.65 | 1.29 | 78 |
| Dialysis | 860 | 116 | 7.41 | 2 | 49 |
| Gel filtration | 273 | 28 | 9.73 | 2.7 | 31 |
Discussion
In present study, the Laccase enzyme production of Bacillus sp were analyzed with various optimization parameters. The high yield of enzyme are noticed such that carbon source (lactose and maltose), Nitrogen source (Beef), Incubation period (96 hours), Temperature (40⁰C) and inducers (Guiacol). The based high yielding undergone the process of mass level production. Finally got partial purification product yield was 31%, mentioned in unit as 9.7 mg/ml.
Among that inorganic nitrogen sources, the highest laccase activity was observed with peptone (0.0382 U/ml) 15, 16. The highest laccase activity was observed at pH 7 (0.0341 U/ml), while lowest laccase activity was observed at pH 12 (0.0287 U/ml) in which highest laccase activity was reported at pH3.The highest laccase activity was observed at 40ºC (0.0388 U/ml) while slight decrease in enzyme activity was observed at 50ºC (0.0382 U/ml) 15.The optimal temperature of laccase differs greatly from one strain to another. Maximum laccase activity (270 ± 2.78 U/mL) of B.subtilisMTCC 2414 was recorded at 30⁰C for rice bran and 40⁰C (233±4.09 U/mL) for wheat bran. 17 and 18 reported that laccase from CotA of B.subtilisand Lentinulaedodes exhibited maximum activity at 40⁰C. The results of the study are in accordance with recent reports which confirmed that laccases fromP. putida are highly stable between 30 and 50⁰C 19.
Conclusion
The laccase are the copper cointaining enzyme and it will have more potential application in many industries like Food, Pharmaceutical, Textile industries. It has especialy having a catalytic and electrocatalytic properties. Laccase has been applied to nanobiotechnology which is an increasing research field and catalyzes electron transfer reactions without additional cofactors. Recently several techniques have been developed for the immobilization of biomolecule such as micropatterning, self-assembled monolayer, and layer-by-layer technique which immobilize laccase and preserve their enzymatic activity. Hence laccase is receiving much attention of researchers around the globe.
References
- 1.Galhaupa C, Wagnera H, Hinterstoisserb B, Haltricha D. (2002) Increased production of laccase wood-by the degrading basidiomyceteTramete pubescens.Enzyme and Microbial Technology. 30, 529-536.
- 2.Higuchi T. (2004) Microbial degradation of lignin role of lignin peroxidase, manganese peroxidase, and laccase. , Proc. Jpn. Acad. Ser. B; 80, 204-214.
- 3.Faure D. (1994) Bouillant ML Bally R Isolation ofAzospirillum lipoferum4T Tn5 mutants affected in melanization and laccase activity. Application of Environmental Microbiology. 60, 3413-3415.
- 4.Mohammadian M, Roudsari M F, Mollania N, Dalfard A B, Khajeh K. (2010) Enhanced expression of a recombinant bacterial laccase at low temperature and micro aerobic conditions: purification and biochemical characterization. , J Ind Microbiol Biotechnol 5, 41-45.
- 5.Arora D S, Sharma R K. (2010) Ligninolytic Fungal Laccases and Their Biotechnological Applications. , Application of Biochemistry and Biotechnology 160, 1760-1788.
- 6.Kirk O, Borchert T V, Fuglsang C C. (2002) Industrial enzyme applications. , Curr Opin Biotechnol; 13, 345-351.
- 7.Poppius-Levlin K, Wang M, Tamminen T, Hortling B, Viikari L et al. (1999) Effects of laccase/HBT treatment on pulp and lignin structures.J. Pulp Paper Sci.25:. 90-94.
- 10.Devasia Sheena, Jayakumaran Nair A. (2016) Screening of Potent Laccase Producing Organisms Based on the. Oxidation Pattern of Different Phenolic Substrates International Journal of Current Microbiology and Applied Sciences 5(5), 127-137.
- 11.Jyotsna Kiran Peter, Vandana Priyam, Masih Harison, Kumar Yashab. (2014) . Production Optimization and Partial Purification of Laccases from Bacterial Consortium. International Journal of Engineering Research & Technology (IJERT). 3( 6): ISSN: 2278-0181.
- 12.Kim S H, Choi N S. (2000) Purification and characterization of subtilisin DJ-4 secreted by Bacillus sp. strain DJ-4 screened from Doen-Jang. Bioscience Biotechnology and Biochemistry. 64, 1722-5.
- 13.O H Lowry, N J Rosebrough, A L Farr, R J. (1951) Protein measurement with the folin phenol reagent. , Journal of general Microbiology 31, 3017-3027.
- 15.Ding T Y, Hii S L, Ong L. (2012) Comparison of pretreatment strategies for conversion of coconut husk fiber to fermentable sugars.BioResources,7(2). 1540-1547.
- 16.Sivakumar R, Rajendran R, Balakumar C, Tamilvendan M. (2010) Isolation, screening and optimization of production medium for thermostable laccase production from Ganoderma sp.Int. , J Eng Sci 2(12), 7133-7141.
- 17.Hullo M-F, Moszer I, Danchin A, Mart´ ın-Verstraete I. (2001) CotA ofBacillus subtilisis a copper- dependent laccase. , Journal of Bacteriology 183(18), 5426-5430.
Cited by (8)
This article has been cited by 8 scholarly works according to:
Citing Articles:
Applied Sciences (2025) OpenAlex
Asemahle Gogotya, N. Nnolim, U. Nwodo - Applied Sciences (2025) Semantic Scholar
B. A. Oyedeji, N. R. Oloye, S. Adebajo, M. O. Taiwo, B. T. Folarin et al. - Bulletin of the National Research Centre (2025) Semantic Scholar
Archives of Microbiology (2024) OpenAlex
Archives of Microbiology (2024) Crossref
Sheetal Pandey, Sarika Gupta - Archives of Microbiology (2024) Semantic Scholar
The holistic approach to environment (2023) OpenAlex
Reports (2023) OpenAlex